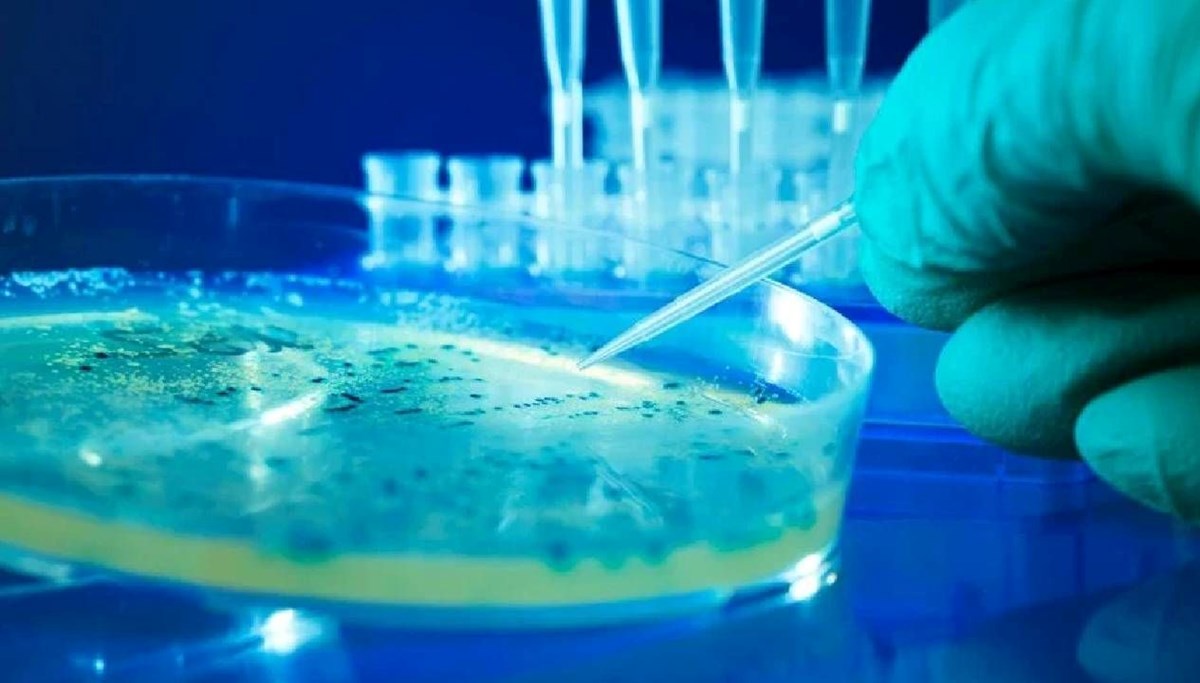
ABD’de salmonella alarmı

ABD Hastalık Kontrol ve Önleme Merkezleri (CDC), evlere yemek servisi yapan “Metabolic Meals” isimli şirketin bazı ürünleriyle bağlantılı bir salmonella salgını tespit edildiğini açıkladı. Salgın, 10 eyalette en az 16 kişiyi etkiledi, 7’si hastaneye kaldırıldı.
ABD’nin Kaliforniya, Missouri, Georgia, Minnesota, Teksas, Arkansas, Illinois, Rhode Island, Wisconsin ve Washington eyaletlerinde salmonella salgını paniği yaşanıyor.
CBC News’in haberine göre salgın tehlikesinin kaynağı ise evlere yemek servisi yapan “Metabolic Meals” isimli şirketin bazı ürünleri.
Risk taşıyan yemeklerin çoğu da tavuk ürünleri.
ABD Hastalık Kontrol ve Önleme Merkezleri (CDC) en az 16 kişiyi etkileyen hastalığın yayılımını doğruladı.
Yetkililer hastalıkların bildirilmesinin genellikle birkaç hafta sürdüğünü belirterek, vaka sayısının artabileceğini vurguladı.
Metabolic Meals şirketi ise yetkililerle işbirliği yaptıklarını ve müşterilerine doğrudan ulaşarak ürünler hakkında bilgilendirme yaptıklarını açıkladı.